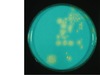

Test 3- Mycobacterium Flashcards
(79 cards)
Mycobacterium
• Gram positive,
• Acid Fast positive bacteria
• Important human and animal pathogen
Mycobacterium spp.
Bacteria that contain mycolic acid and have a unique peptidoglycan chemotype

stain lightly gram positive

Acid Fast stain positive
Mycolic Acids
Fatty acids in the cell wall
Carbon chain length varies by Genus
Rapid-growing Mycobacterium spp have shortest chains Slow-growing Mycobacterium spp. have Longest chains Corynebacterium has the shortest
mycobacterium have the longest
Properties Attributed to Mycolic Acid in Mycobacteria
Acid fast staining
Drug, chemical and environmental resistance
Immunomodulating activities
(lipoarabinomannan, lipoarabinogalactan, wax D)
Prevent phagocytic killing- why they can survive in the cell
(trehalose dimycolate - cord factor)
(phenolic glycolipid - scavenger of oxygen radicals) (sulphated glycolipids - prevent lysosome fusion)
Acid Fast Stain
A differential stain that uses a lipid permeablizing first step (with heat or chemical solvent);
- Primary stain
- An acidic alcohol decolorizing step
- A counter stain
(Carbol fuschin>decolorizer>Methylene Blue) Examples
Ziehl-Neelsen Stain
Kinyons stain
Auramine Rhodamine stain(Fluorescent based stain- Very sensitive) for TB
Habitat of Mycobacterium spp.
Some species are obligate pathogens- always ass with disease
(M. tuberculosis complex, M. avium subsp paratuberculosis, M. leprae, M. lepraemurium)
- *Opportunistic Pathogens**- present in the soil and water
- *Many species are soil / water saprophytes**
(rapid-growers, M. avium complex, M. kansasii, M. intracellulare, etc.)
Under optimum conditions obligate pathogens can survive in a contaminated environment for extended periods
Identification of Mycobacterium sp.
Runyongroups:
Growth patterns:
Photochromogens (pigmented in the presence of light)
Scotochromogens (pigmented in the absence of light) Non-Chromogens
Rapid growers (\< 7 days) Slow growers (2-10 weeks) Mycobactin dependent (exogenous siderophore)
Biochemical patterns (limited specialty techniques)
Total cell fatty acid analysis
Nucleic acid detection (DNA probes/PCR)
DON’T HAVE TO REMEMBER THIS SLIDE
Mycobacterium Virulence Factors
1. Mycolic acid containing cell wall lipids
Facilitate Survival in macrophage (Facultative intracellular Pathogens) Stimulate cytokine production
Enhance Adjuvant / immunomodulating effects
2. Cell protein antigens
Tuberculin> purified protein derivative > specific tuberculoproteins
Protein exotoxins and extracellular enzymes generally do not play a prominent role in disease pathogenesis
(except M. ulcerans – mycolactone(-mycins antiboditics)/macrolide toxin)
Diseases caused by Mycobacterium spp.
• Mammalian tuberculosis:
Avian tuberculosis:(M. avium subsp. avium serotypes 1-3)
Leprosy: M. leprae (human), M. lepraemurium (cat)
Johne’s disease: M. avium subsp. paratuberculosis
(M. tuberculosis complex –M. tuberculosis, M. bovis, M. africanum, M.microti)
M. tuberculosis
• Humans are the main reservoirs
• Tuberculosis (TB) is second only to HIV/AIDS as the greatest killer worldwide due to a single infectious agent.
Emerging zoonosis and anthropozoonosis
• Dogs, cats, pigs, nonhuman primates
• Psittacine birds and canaries are susceptible to tuberculosis
Elephant-to-Human Transmission of Tuberculosis Endemic infections in some wild life populations
Eg. Banded Mongoose in Botswana
Suricates in south Africa
Drug resistant
Multidrug resistant TB (MDR-TB)
Resistant to at least isoniazid and rifampin
Extensively Drug resistant TB (XDR)
Resistant to isoniazid and rifampin, plus any fluoroquinolone and at least one of three injectable second-line drugs (i.e., amikacin, kanamycin, or capreomycin).
Mycobacterium bovis
Cause zoonotic TB
Ingestion, inhalation and, less frequently, by contact with mucous membranes and broken skin.
Wide host range and geographic distribution
GI tract is the main portal of entry
MI and Texas- DEER
M. bovis: Host range
host range: Ireland & UK(badgers), New Zealand(
Maintained primarily in bovine species but has the broadest host range of all TB organisms and can infect several wildlife species (especially cervids in US)
Usually survives only a few weeks outside of host
Causes disease indistinguishable from that of M. tuberculosis in humans
Transmission of M. bovis
cattle- any organ
cats- get via ingestion
dog- get from humans or ingestion
birds


TB in wild deer
can also be in the lymphnode as shown below
THESE ARE GRANULOMAS

Other reservoirs of Mycobacterium bovis
- Badgers in UK
- Feral Brush tail possums: New Zealand
M. bovis infection (bovine tuberculosis)
Chronic, progressive and latent infections
Disease is seldom apparent until it has reached advanced stages (months)
Some infected livestock appear in prime condition showing no evidence of infection until slaughtered and then may be so severely affected that the carcass is condemned
In some cases the organisms remain dormant in the body for lifetime without causing progressive disease
M. bovis: Transmission
• Aerosol transmission most common among
cattle (greatest risk occurs in enclosed or crowded areas eg. barns,, markets, shared watering/feeding places)
- *• May be shed in milk** (most human infections prior to widespread pasteurization resulted from drinking or handling contaminated milk)
- *• Can enter body at any site**
AEROSOL AND INGESTION- MOST COMMON
M. bovis: Clinical Signs
Signs vary greatly with extent of exposure and site of infection
Enlarged regional lymph nodes and generalized wasting (cachexia) are seen in advanced disease stages. Pulmonary forms may be associated with chronic cough
M. bovis: Pathology
May cause lesions in any organ
In early stages lesions difficult to find at necropsy
Some early lesions may grossly appear abscess-like
In later stages firm, nodular lesions become evident in target organs and associated lymph nodes (lungs, head, gastrointestinal)
MAIN LESION IS GRANULOMA IN MYCOBACTERIA(INCLUDING TB)
Pathogenesis
Bacilli are phagocytosed by macrophages>Infected macrophages secrete TNF-alpha and IL-12>T-helper 1 lymphocyte activity and >secretion of INF-gamma and
IL-2 >Cell mediated immunity and destruction of bacilli
If the bacilli survive, infected macrophages are killed following stimulated release of macrophage-derived cytotoxins and enzymes (type IV hypersensitivity or Delayed type hypersensitivity), which leads to tissue destruction and caseous necrosis WITH MINERALIZATION
Liquefaction and cavity formation result from enzymatic action.
Rupture of these cavities allows dissemination.